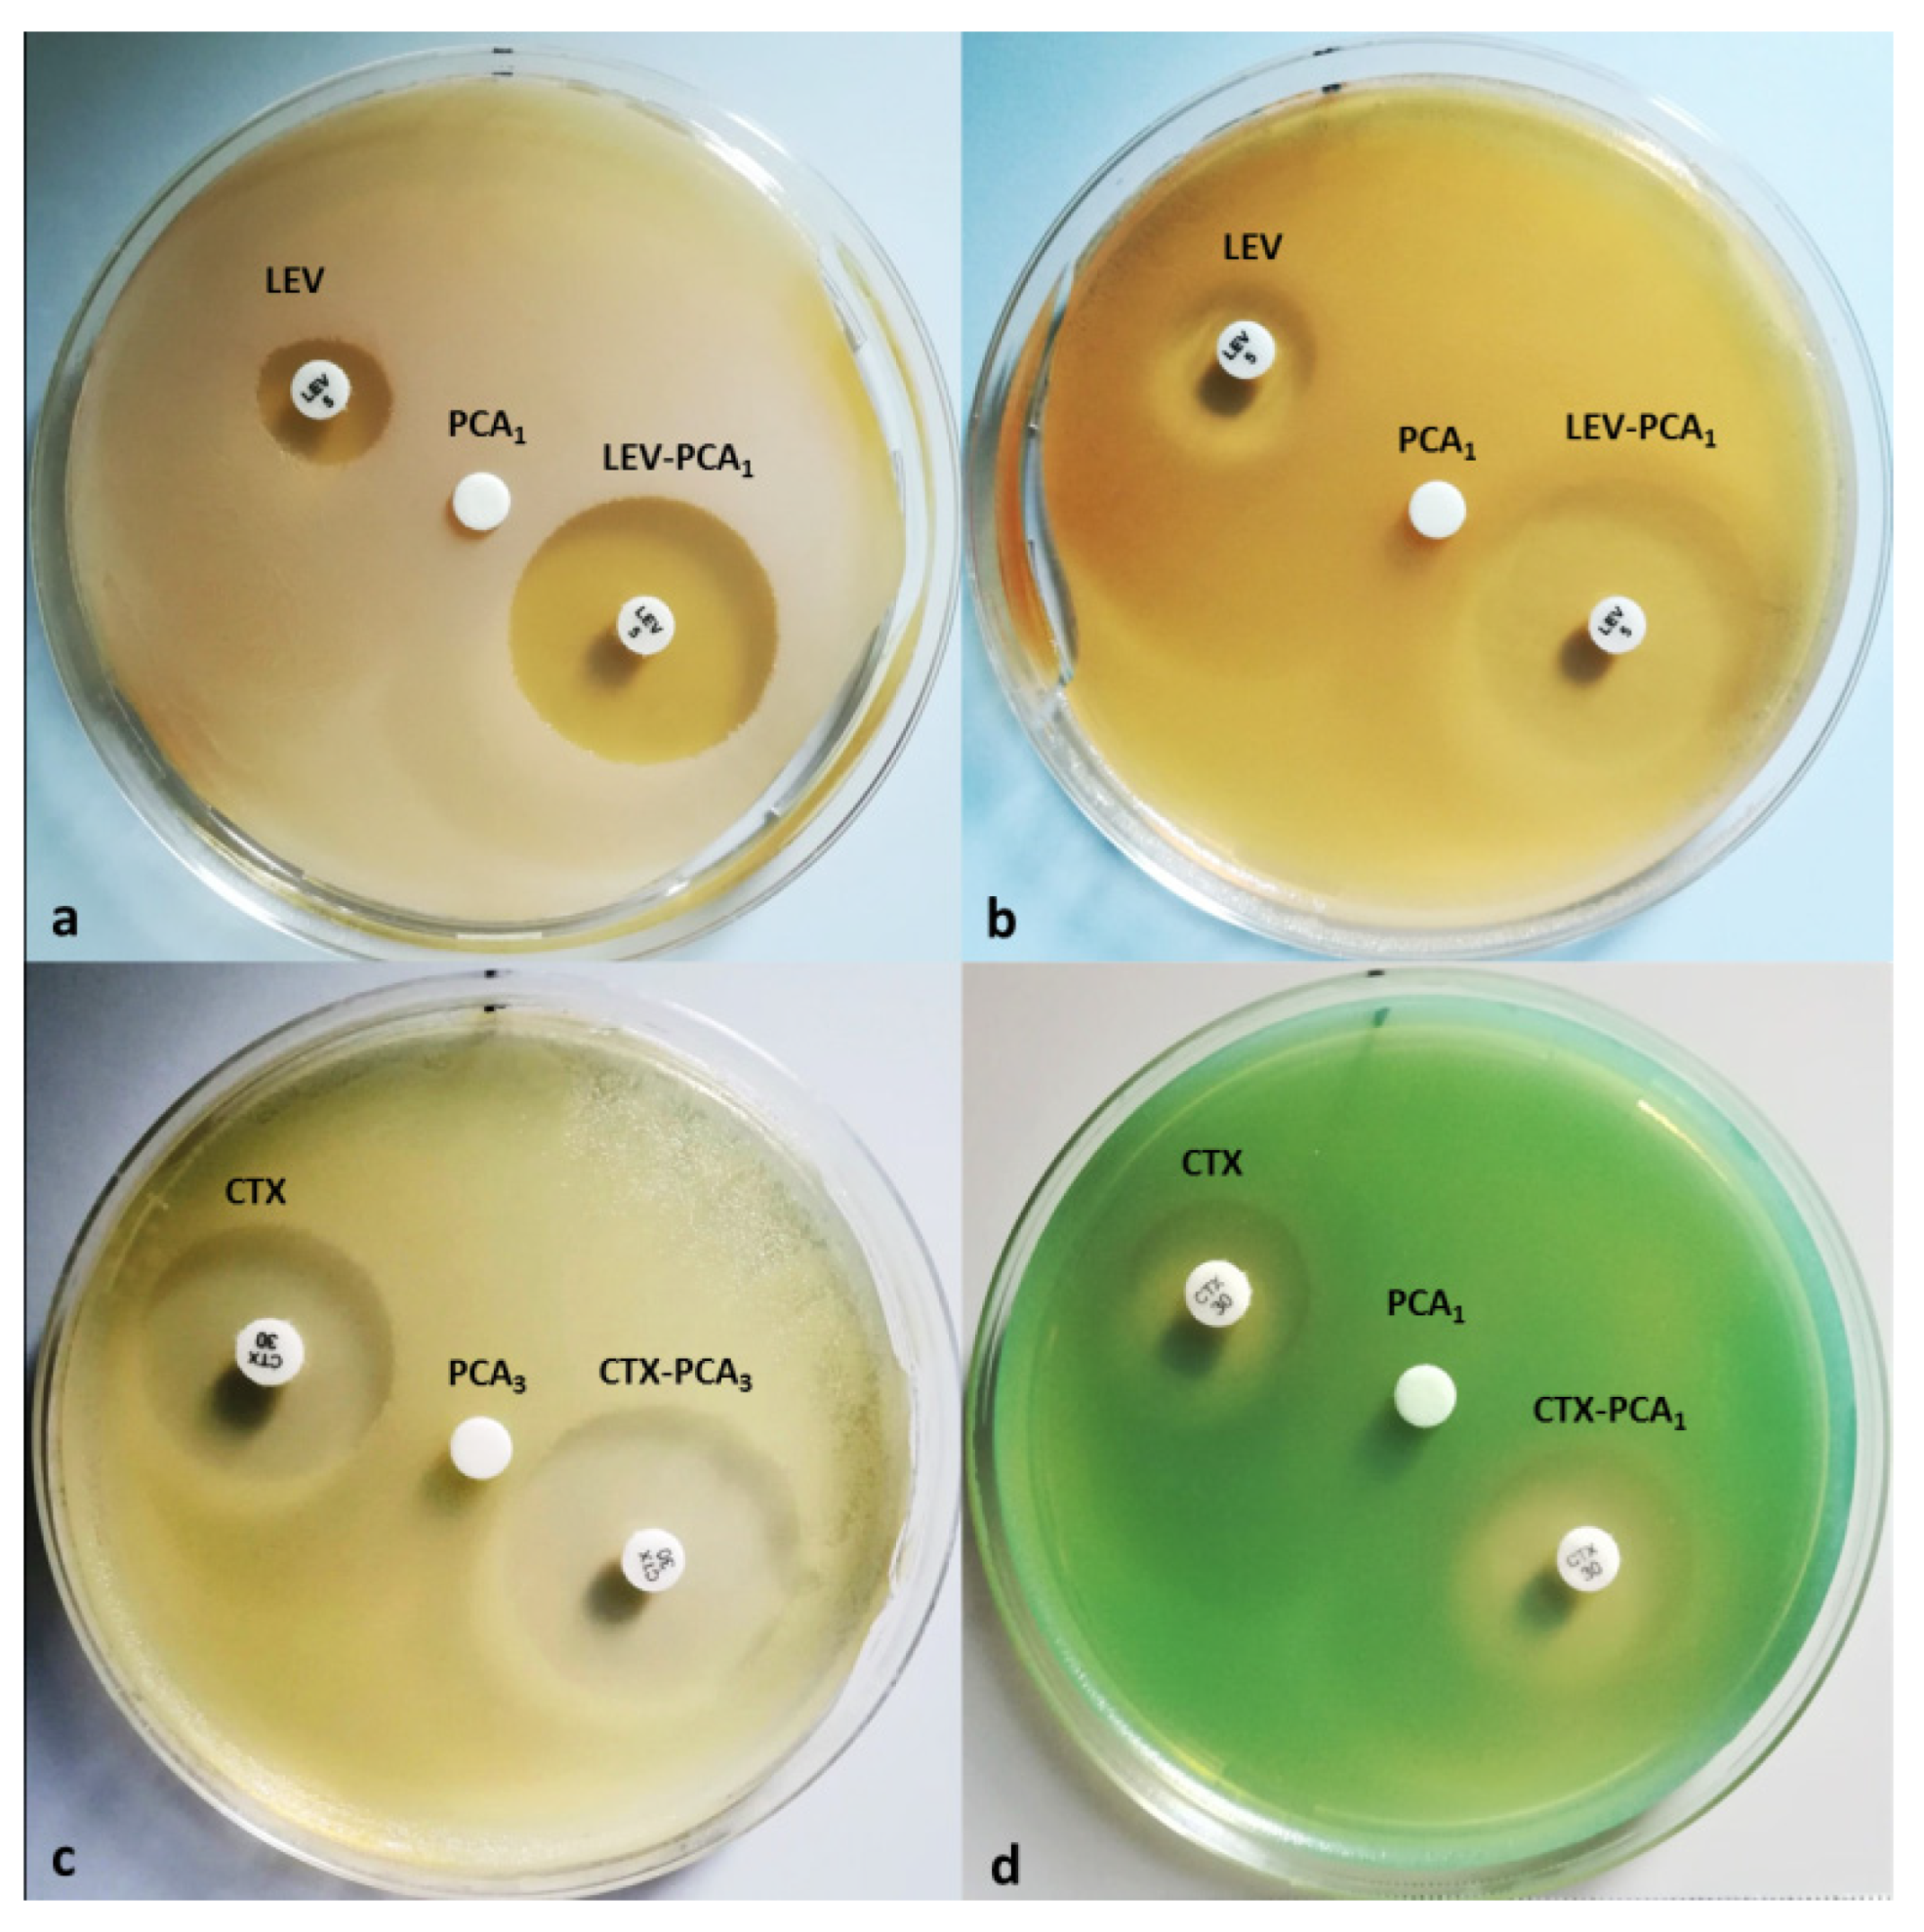
Life 12 01010 g001

Does Protocatechuic Acid Affect the Activity of Commonly Used Antibiotics and Antifungals?
Abstract
:1. Introduction
2. Materials and Methods
2.1. Materials
2.2. Methods
2.3. Statistical Analysis
3. Results
4. Discussion
5. Conclusions
Author Contributions
Funding
Conflicts of Interest
References
- del Pozo, J.L.; Patel, R. The Challenge of Treating Biofilm-Associated Bacterial Infections. Clin. Pharmacol. Ther. 2007, 82, 204–209. [Google Scholar] [CrossRef] [PubMed]
- Antimicrobial Resistance: Tackling a Crisis for the Health and Wealth of Nations/the Review on Antimicrobial Resistance Chaired by Jim O’Neill. Available online: https://wellcomecollection.org/works/rdpck35v (accessed on 21 February 2022).
- Roemhild, R.; Linkevicius, M.; Andersson, D.I. Molecular Mechanisms of Collateral Sensitivity to the Antibiotic Nitrofurantoin. PLoS Biol. 2020, 18, e3000612. [Google Scholar] [CrossRef] [PubMed] [Green Version]
- Dortet, L.; Cuzon, G.; Ponties, V.; Nordmann, P. Trends in Carbapenemase-Producing Enterobacteriaceae, France, 2012 to 2014. Eurosurveillance 2017, 22, 30461. [Google Scholar] [CrossRef] [PubMed]
- Llor, C.; Bjerrum, L. Antimicrobial Resistance: Risk Associated with Antibiotic Overuse and Initiatives to Reduce the Problem. Ther. Adv. Drug Saf. 2014, 5, 229–241. [Google Scholar] [CrossRef] [PubMed] [Green Version]
- Mizrahi, A.; Delerue, T.; Morel, H.; Le Monnier, A.; Carbonnelle, E.; Pilmis, B.; Zahar, J.R. Infections Caused by Naturally AmpC-Producing Enterobacteriaceae: Can We Use Third-Generation Cephalosporins? A Narrative Review. Int. J. Antimicrob. Agents 2020, 55, 105834. [Google Scholar] [CrossRef]
- Xu, Q.; Fu, Y.; Ji, J.; Du, X.; Yu, Y. In Vitro Effect of the Combination of Aztreonam and Amoxicillin/Clavulanic Acid Against Carbapenem-Resistant Gram-Negative Organisms Producing Metallo-β-Lactamase. IDR 2021, 14, 833–839. [Google Scholar] [CrossRef]
- D’Arcy, P.F. Nitrofurantoin. Drug Intell. Clin. Pharm. 1985, 19, 540–547. [Google Scholar] [CrossRef]
- Howard, B. Nitrofurantoin. In xPharm: The Comprehensive Pharmacology Reference; Enna, S.J., Bylund, D.B., Eds.; Elsevier: New York, NY, USA, 2007; pp. 1–6. ISBN 978-0-08-055232-3. [Google Scholar]
- Wijma, R.A.; Huttner, A.; Koch, B.C.P.; Mouton, J.W.; Muller, A.E. Review of the Pharmacokinetic Properties of Nitrofurantoin and Nitroxoline. J. Antimicrob. Chemother. 2018, 73, 2916–2926. [Google Scholar] [CrossRef]
- Darrell, J.H.; Garrod, L.P.; Waterworth, P.M. Trimethoprim: Laboratory and Clinical Studies. J. Clin. Pathol. 1968, 21, 202–209. [Google Scholar] [CrossRef] [Green Version]
- Bhosle, A.; Datey, A.; Chandrasekharan, G.; Singh, D.; Chakravortty, D.; Chandra, N. A Strategic Target Rescues Trimethoprim Sensitivity in Escherichia coli. IScience 2020, 23, 100986. [Google Scholar] [CrossRef]
- Song, Y.; Zhou, Z.; Gu, J.; Yang, J.; Deng, J. Reducing the Periplasmic Glutathione Content Makes Escherichia coli Resistant to Trimethoprim and Other Antimicrobial Drugs. Microbiol. Spectr. 2021, 9, e00743-21. [Google Scholar] [CrossRef] [PubMed]
- Oumer, Y.; Regasa Dadi, B.; Seid, M.; Biresaw, G.; Manilal, A. Catheter-Associated Urinary Tract Infection: Incidence, Associated Factors and Drug Resistance Patterns of Bacterial Isolates in Southern Ethiopia. Infect. Drug Resist. 2021, 14, 2883–2894. [Google Scholar] [CrossRef] [PubMed]
- Ramdhani, D.; Azizah, S.N.; Kusuma, S.A.F.; Sediana, D. Antibiotic Resistance: Evaluation of Levofloxacin Treatment in Acute Respiratory Tract Infections Cases at the Tasikmalaya City Health Center, Indonesia. J. Adv. Pharm. Technol. Res. 2020, 11, 113–116. [Google Scholar] [CrossRef]
- Park, N.-H.; Shin, K.-H.; Kang, M.K. 34—Antifungal and Antiviral Agents. In Pharmacology and Therapeutics for Dentistry, 7th ed.; Dowd, F.J., Johnson, B.S., Mariotti, A.J., Eds.; Mosby: Tokyo, Japan, 2017; pp. 488–503. ISBN 978-0-323-39307-2. [Google Scholar]
- Zhu, C.; Liao, B.; Ye, X.; Zhou, Y.; Chen, X.; Liao, M.; Cheng, L.; Zhou, X.; Ren, B. Artemisinin Elevates Ergosterol Levels of Candida Albicans to Synergise with Amphotericin B against Oral Candidiasis. Int. J. Antimicrob. Agents 2021, 58, 106394. [Google Scholar] [CrossRef] [PubMed]
- Thompson, G.R.; Cadena, J.; Patterson, T.F. Overview of Antifungal Agents. Clin. Chest Med. 2009, 30, 203–215. [Google Scholar] [CrossRef]
- Revie, N.M.; Iyer, K.R.; Robbins, N.; Cowen, L.E. Antifungal Drug Resistance: Evolution, Mechanisms and Impact. Curr. Opin. Microbiol. 2018, 45, 70–76. [Google Scholar] [CrossRef]
- Van Daele, R.; Spriet, I.; Wauters, J.; Maertens, J.; Mercier, T.; Van Hecke, S.; Brüggemann, R. Antifungal Drugs: What Brings the Future? Med. Mycol. 2019, 57, S328–S343. [Google Scholar] [CrossRef] [Green Version]
- Kakkar, S.; Bais, S. A Review on Protocatechuic Acid and Its Pharmacological Potential. ISRN Pharm. 2014, 2014, 952943. [Google Scholar] [CrossRef] [Green Version]
- Ellnain-Wojtaszek, M. Phenolic Acids from Ginkgo Biloba L. Part II. Quantitative Analysis of Free and Liberated by Hydrolysis Phenolic Acids. Acta Pol. Pharm. 1997, 54, 229–232. [Google Scholar]
- Khan, A.K.; Rashid, R.; Fatima, N.; Mahmood, S.; Mir, S.; Khan, S.; Jabeen, N.; Murtaza, G. Pharmacological Activities Of Protocatechuic Acid. Acta Pol. Pharm. 2015, 72, 643–650. [Google Scholar]
- Li, X.; Wang, X.; Chen, D.; Chen, S. Antioxidant Activity and Mechanism of Protocatechuic Acid in Vitro. Funct. Foods Health Dis. 2011, 1, 232–244. [Google Scholar] [CrossRef]
- Chao, C.-Y.; Yin, M.-C. Antibacterial Effects of Roselle Calyx Extracts and Protocatechuic Acid in Ground Beef and Apple Juice. Foodborne Pathog. Dis. 2009, 6, 201–206. [Google Scholar] [CrossRef] [PubMed] [Green Version]
- Zhou, Z.; Zhang, Y.; Ding, X.-R.; Chen, S.-H.; Yang, J.; Wang, X.-J.; Jia, G.-L.; Chen, H.-S.; Bo, X.-C.; Wang, S.-Q. Protocatechuic Aldehyde Inhibits Hepatitis B Virus Replication Both in Vitro and in Vivo. Antiviral. Res. 2007, 74, 59–64. [Google Scholar] [CrossRef]
- Lungoci, A.-L.; Turin-Moleavin, I.-A.; Corciova, A.; Mircea, C.; Arvinte, A.; Fifere, A.; Marangoci, N.L.; Pinteala, M. Multifunctional Magnetic Cargo-Complexes with Radical Scavenging Properties. Mater. Sci. Eng. C Mater. Biol. Appl. 2019, 94, 608–618. [Google Scholar] [CrossRef] [PubMed]
- Tudorachi, N.B.; Totu, E.E.; Fifere, A.; Ardeleanu, V.; Mocanu, V.; Mircea, C.; Isildak, I.; Smilkov, K.; Cărăuşu, E.M. The Implication of Reactive Oxygen Species and Antioxidants in Knee Osteoarthritis. Antioxidants 2021, 10, 985. [Google Scholar] [CrossRef] [PubMed]
- Anghelache, M.; Turtoi, M.; Petrovici, A.R.; Fifere, A.; Pinteala, M.; Calin, M. Development of Dextran-Coated Magnetic Nanoparticles Loaded with Protocatechuic Acid for Vascular Inflammation Therapy. Pharmaceutics 2021, 13, 1414. [Google Scholar] [CrossRef]
- Rosca, I.; Ursu, E.-L.; Fifere, A. A Microbiological Epilogue—Nosocomial Infections. In New Trends in Macromolecular and Supramolecular Chemistry for Biological Applications; Abadie, M.J.M., Pinteala, M., Rotaru, A., Eds.; Springer International Publishing: Cham, Switzerland, 2021; pp. 179–189. ISBN 978-3-030-57456-7. [Google Scholar]
- Bauer, A.; Perry, D.M.; Kirby, W.M. Single-Disk Antibiotic-Sensitivity Testing of Staphylococci; an Analysis of Technique and Results. AMA Arch. Intern. Med. 1959, 104, 208–216. [Google Scholar] [CrossRef]
- CLSI M100-Ed30—Performance Standards for Antimicrobial Susceptibility Testing—30th Edition. Available online: https://webstore.ansi.org/standards/clsi/clsim100ed30?gclid=EAIaIQobChMI3fPXm7WT9wIVlo9oCR0GbwhLEAAYAyAAEgIvR_D_BwE (accessed on 14 April 2022).
- ImageJ. Available online: https://imagej.nih.gov/ij/ (accessed on 22 February 2022).
- XLSTAT|Statistical Software for Excel. Available online: https://www.xlstat.com/en/?creative=451050327512&keyword=xlstat&matchtype=e&network=g&device=c&gclid=EAIaIQobChMIpLTi7pL28QIVAbp3Ch2cxgUMEAAYASAAEgKae_D_BwE (accessed on 22 July 2021).
- AlSheikh, H.M.A.; Sultan, I.; Kumar, V.; Rather, I.A.; Al-Sheikh, H.; Tasleem Jan, A.; Haq, Q.M.R. Plant-Based Phytochemicals as Possible Alternative to Antibiotics in Combating Bacterial Drug Resistance. Antibiotics 2020, 9, 480. [Google Scholar] [CrossRef]
- Lim, T.K. Cibotium Barometz. In Edible Medicinal and Non-Medicinal Plants: Volume 10, Modified Stems, Roots, Bulbs; Lim, T.K., Ed.; Springer Netherlands: Dordrecht, The Netherlands, 2016; pp. 82–91. ISBN 978-94-017-7276-1. [Google Scholar]
- Izquierdo-Vega, J.A.; Arteaga-Badillo, D.A.; Sánchez-Gutiérrez, M.; Morales-González, J.A.; Vargas-Mendoza, N.; Gómez-Aldapa, C.A.; Castro-Rosas, J.; Delgado-Olivares, L.; Madrigal-Bujaidar, E.; Madrigal-Santillán, E. Organic Acids from Roselle (Hibiscus Sabdariffa L.)—A Brief Review of Its Pharmacological Effects. Biomedicines 2020, 8, 100. [Google Scholar] [CrossRef]
- Kumar, M.; Barbhai, M.D.; Hasan, M.; Punia, S.; Dhumal, S.; Rais, N.; Chandran, D.; Pandiselvam, R.; Kothakota, A.; Tomar, M.; et al. Onion (Allium Cepa L.) Peels: A Review on Bioactive Compounds and Biomedical Activities. Biomed. Pharmacother. 2022, 146, 112498. [Google Scholar] [CrossRef]
- Juurlink, B.H.; Azouz, H.J.; Aldalati, A.M.; AlTinawi, B.M.; Ganguly, P. Hydroxybenzoic Acid Isomers and the Cardiovascular System. Nutr. J. 2014, 13, 63. [Google Scholar] [CrossRef] [PubMed]
- Borges, A.; Ferreira, C.; Saavedra, M.J.; Simões, M. Antibacterial Activity and Mode of Action of Ferulic and Gallic Acids Against Pathogenic Bacteria. Microb. Drug Resist. 2013, 19, 256–265. [Google Scholar] [CrossRef] [PubMed]
- Semaming, Y.; Pannengpetch, P.; Chattipakorn, S.C.; Chattipakorn, N. Pharmacological Properties of Protocatechuic Acid and Its Potential Roles as Complementary Medicine. Evid. Based Complementary Altern. Med. 2015, 2015, e593902. [Google Scholar] [CrossRef] [PubMed] [Green Version]
- Liu, J.; Du, C.; Beaman, H.T.; Monroe, M.B.B. Characterization of Phenolic Acid Antimicrobial and Antioxidant Structure–Property Relationships. Pharmaceutics 2020, 12, 419. [Google Scholar] [CrossRef]
- Chai, B.; Jiang, W.; Hu, M.; Wu, Y.; Si, H. In Vitro Synergistic Interactions of Protocatechuic Acid and Chlorogenic Acid in Combination with Antibiotics against Animal Pathogens. Synergy 2019, 9, 100055. [Google Scholar] [CrossRef]
- Hidalgo, G.; Chan, M.; Tufenkji, N. Inhibition of Escherichia coli CFT073 FliC Expression and Motility by Cranberry Materials. Appl. Environ. Microbiol. 2011, 77, 6852–6857. [Google Scholar] [CrossRef] [Green Version]
- Bernal-Mercado, A.T.; Gutierrez-Pacheco, M.M.; Encinas-Basurto, D.; Mata-Haro, V.; Lopez-Zavala, A.A.; Islas-Osuna, M.A.; Gonzalez-Aguilar, G.A.; Ayala-Zavala, J.F. Synergistic Mode of Action of Catechin, Vanillic and Protocatechuic Acids to Inhibit the Adhesion of Uropathogenic Escherichia Coli on Silicone Surfaces. J. Appl. Microbiol. 2020, 128, 387–400. [Google Scholar] [CrossRef]
- Cowan, M.M. Plant Products as Antimicrobial Agents. Clin. Microbiol. Rev. 1999, 12, 564–582. [Google Scholar] [CrossRef] [Green Version]
- Sanhueza, L.; Melo, R.; Montero, R.; Maisey, K.; Mendoza, L.; Wilkens, M. Synergistic Interactions between Phenolic Compounds Identified in Grape Pomace Extract with Antibiotics of Different Classes against Staphylococcus aureus and Escherichia coli. PLoS ONE 2017, 12, e0172273. [Google Scholar] [CrossRef]
- Jayaraman, P.; Sakharkar, M.K.; Lim, C.S.; Tang, T.H.; Sakharkar, K.R. Activity and Interactions of Antibiotic and Phytochemical Combinations against Pseudomonas aeruginosa in Vitro. Int. J. Biol. Sci. 2010, 6, 556–568. [Google Scholar] [CrossRef] [Green Version]
- Kyaw, B.M.; Arora, S.; Lim, C.S. Bactericidal Antibiotic-Phytochemical Combinations against Methicillin Resistant Staphylococcus aureus. Braz. J. Microbiol. 2012, 43, 938–945. [Google Scholar] [CrossRef] [PubMed] [Green Version]
| Tested Drugs | Staphylococcus aureus | Escherichia coli | Pseudomonas aeruginosa | |||
|---|---|---|---|---|---|---|
| Inhibition Zone | % * | Inhibition Zone | % * | Inhibition Zone | % * | |
| AMC | 37.75 ± 0.56 | - | 22.06 ± 0.71 | - | - | - |
| CAZ | 16.01 ± 0.46 | - | 29.82 ± 0.74 | - | 31.56 ± 0.85 | - |
| CTX | 29.04 ± 0.17 | - | 28.13 ± 0.59 | - | 19.26 ± 0.61 | - |
| GEN | 19.62 ± 0.28 | - | 19.49 ± 0.85 | - | 17.40 ± 0.63 | - |
| LEV | 20.66 ± 0.91 | - | 29.84 ± 0.13 | - | 23.48 ± 0.84 | - |
| NIT | 19.96 ± 0.09 | - | 22.86 ± 0.01 | - | - | - |
| COT | 23.73 ± 0.21 | - | 23.05 ± 0.60 | - | - | - |
| PCA1 | 0 | 0 | 0 | 0 | 0 | 0 |
| PCA2 | 0 | 0 | 0 | 0 | 0 | 0 |
| PCA3 | 0 | 0 | 0 | 0 | 0 | 0 |
| AMC-PCA1 | 39.85 ± 0.05 | 5.57 | 22.07 ± 0.01 | 0.10 | - | - |
| AMC-PCA2 | 40.74 ± 0.12 | 7.93 | 22.46 ± 0.07 | 1.79 | - | - |
| AMC-PCA3 | 43.16 ± 0.52 | 14.33 | 22.80 ± 0.04 | 3.33 | - | - |
| CAZ-PCA1 | 14.97 ± 0.13 | −6.48 | 28.03 ± 0.08 | −6.00 | 30.36 ± 0.03 | −3.80 |
| CAZ-PCA2 | 16.15 ± 0.05 | 0.89 | 30.22 ± 0.23 | 1.34 | 29.77 ± 0.29 | −5.67 |
| CAZ-PCA3 | 14.98 ± 0.15 | −6.43 | 29.76 ± 0.12 | −0.25 | 32.85 ± 0.26 | 4.09 |
| CTX-PCA1 | 31.31 ± 0.05 | 7.78 | 28.99 ± 0.35 | 3.04 | 21.88 ± 0.55 | 13.59 |
| CTX-PCA2 | 30.45 ± 0.12 | 4.84 | 28.88 ± 0.25 | 2.66 | 19.35 ± 0.15 | 0.48 |
| CTX-PCA3 | 29.55 ± 0.02 | 5.36 | 33.85 ± 0.32 | 20.30 | 19.04 ± 0.02 | −1.34 |
| GEN-PCA1 | 35.02 ± 0.01 | 20.55 | 19.26 ± 0.08 | −1.14 | 19.21 ± 0.10 | 10.49 |
| GEN-PCA2 | 23.18 ± 0.02 | −20.18 | 19.76 ± 0.05 | 1.39 | 16.56 ± 0.02 | −4.84 |
| GEN-PCA3 | 24.92 ± 0.05 | −14.20 | 19.47 ± 0.12 | −0.09 | 17.81 ± 0.08 | 2.34 |
| LEV-PCA1 | 32.24 ± 0.01 | 55.98 | 38.34 ± 0.37 | 28.45 | 28.43 ± 0.03 | 15.25 |
| LEV-PCA2 | 35.79 ± 0.04 | 43.15 | 32.68 ± 0.28 | 10.11 | 25.02 ± 0.04 | 4.95 |
| LEV-PCA3 | 34.84 ± 0.45 | 38.60 | 29.67 ± 0.50 | −0.56 | 26.38 ± 0.10 | 10.65 |
| NIT-PCA1 | 18.10 ± 0.22 | −9.29 | 28.84 ± 0.26 | 26.13 | - | - |
| NIT-PCA2 | 19.86 ± 0.04 | −0.47 | 24.15 ± 0.08 | 5.61 | - | - |
| NIT-PCA3 | 19.57 ± 0.02 | −1.93 | 24.33 ± 0.20 | 6.40 | - | - |
| COT-PCA1 | 24.92 ± 0.12 | 5.01 | 29.87 ± 0.08 | 29.66 | - | - |
| COT-PCA2 | 24.24 ± 0.03 | 2.13 | 23.85 ± 0.07 | 3.45 | - | - |
| COT-PCA3 | 24.64 ± 0.58 | 3.83 | 23.81 ± 0.29 | 3.27 | - | - |
| Tested Drug | Candida albicans | |
|---|---|---|
| Inhibition Zone | % * | |
| AP | 20.59 ± 0.37 | - |
| NS | 23.22 ± 0.29 | - |
| ECO | 21.30 ± 0.68 | - |
| KT | 18.46 ± 0.29 | - |
| FLC | 28.07 ± 0.69 | - |
| PCA1 | 0 | 0 |
| PCA2 | 0 | 0 |
| PCA3 | 0 | 0 |
| AP-PCA1 | 16.18 ± 0.08 | −2.28 |
| AP-PCA2 | 20.16 ± 0.05 | −1.91 |
| AP-PCA3 | 20.86 ± 0.12 | 1.49 |
| NS-PCA1 | 24.77 ± 0.45 | 6.66 |
| NS-PCA2 | 24.03 ± 0.25 | 3.45 |
| NS-PCA3 | 21.22 ± 0.18 | −8.62 |
| ECO-PCA1 | 19.05 ± 0.07 | −1.52 |
| ECO-PCA2 | 19.61 ± 0.12 | −7.93 |
| ECO-PCA3 | 19.67 ± 0.35 | −7.66 |
| KT-PCA1 | 17.76 ± 0.07 | −3.81 |
| KT-PCA2 | 18.75 ± 0.27 | 1.58 |
| KT-PCA3 | 19.23 ± 0.14 | 4.18 |
| FLC-PCA1 | 26.91 ± 0.12 | −4.15 |
| FLC-PCA2 | 26.08 ± 0.11 | −7.36 |
| FLC-PCA3 | 26.05 ± 0.07 | −7.37 |
Publisher’s Note: MDPI stays neutral with regard to jurisdictional claims in published maps and institutional affiliations. |
© 2022 by the authors. Licensee MDPI, Basel, Switzerland. This article is an open access article distributed under the terms and conditions of the Creative Commons Attribution (CC BY) license (https://creativecommons.org/licenses/by/4.0/).
Share and Cite
Fifere, A.; Turin-Moleavin, I.-A.; Rosca, I. Does Protocatechuic Acid Affect the Activity of Commonly Used Antibiotics and Antifungals? Life 2022, 12, 1010. https://doi.org/10.3390/life12071010
Fifere A, Turin-Moleavin I-A, Rosca I. Does Protocatechuic Acid Affect the Activity of Commonly Used Antibiotics and Antifungals? Life. 2022; 12(7):1010. https://doi.org/10.3390/life12071010
Chicago/Turabian StyleFifere, Adrian, Ioana-Andreea Turin-Moleavin, and Irina Rosca. 2022. "Does Protocatechuic Acid Affect the Activity of Commonly Used Antibiotics and Antifungals?" Life 12, no. 7: 1010. https://doi.org/10.3390/life12071010
APA StyleFifere, A., Turin-Moleavin, I.-A., & Rosca, I. (2022). Does Protocatechuic Acid Affect the Activity of Commonly Used Antibiotics and Antifungals? Life, 12(7), 1010. https://doi.org/10.3390/life12071010

